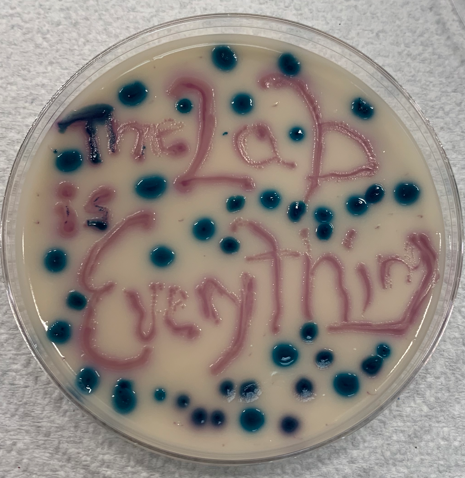
Petri dish art

Public Health Laboratory
The County of San Luis Obispo Public Health Laboratory provides clinical and environmental testing to support programs of the Health Agency as well as hospitals, clinics, physicians, private businesses, citizens, and local, State, and Federal authorities.
Services and information:
- Tests and fees
- Biothreat testing
- Courier services
- Requisitions
- Laboratory licenses and certifications
- Non-diagnostic general health assessment certification
- Web portal
- Phone numbers
- Requirements for laboratories to report test results
- Laboratory Messenger
- Hot topics
Location
2191 Johnson Avenue
San Luis Obispo, CA 93401
Phone: (805) 781-5507
Fax: (805) 781-1023
Hours of Operation
Monday through Friday, 8 am to 5 pm
On-call during weekends and holidays
Laboratory Director
Glen M. Miller, PhD, HCLD(ABB)
Phone: (805) 781-5512
Email: [email protected]